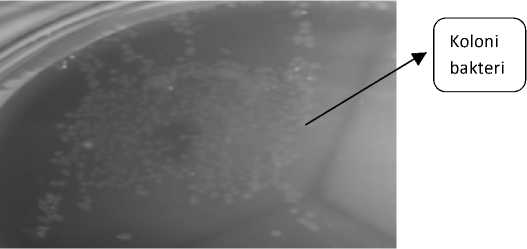

IDENTIFIKASI BAKTERI DARI IKAN TONGKOL (Euthynnus affinis) YANG DIPERDAGANGKAN DI PASAR IKAN KEDONGANAN BALI
on
JURNAL BIOLOGI VOLUME 19 NO.2 DESEMBER 2015
IDENTIFIKASI BAKTERI DARI IKAN TONGKOL (Euthynnus affinis) YANG DIPERDAGANGKAN DI PASAR IKAN KEDONGANAN BALI
IDENTIFICATION OF BACTERIA FROM TONGKOL FISH (Euthynnus affinis) TRADED AT KEDONGANAN FISH MARKET BALI
Gusti Ayu Dianti Violentina1*), Yan Ramona1, I Gusti Ngurah Kade Mahardika2
1Jurusan Biologi FMIPA Universitas Udayana, Bukit Jimbaran – Bali;
2Fakultas Kedokteran Hewan Universitas Udayana, Jl. Sudirman, Denpasar
*Email : dviolentina@yahoo.com
INTISARI
Ikan tongkol (Euthynnus affinis) merupakan ikan konsumsi yang disukai masyarakat.Pengetahuan tentang bakteri yang ditemukan pada tubuh ikan ini sangat penting untuk tujuan kesehatan masyarakat dan kajian biologi ikan. Penelitian ini bertujuan untuk mengidentifikasi bakteri yang berasosiasi dengan ikan tersebut.Bakteri dari usus ikan diambil secara aseptis dan ditumbuhkan pada Blood Agar dan Nutrient Broth. DNA total dari kultur agar cair diisolasi dengan chelax, gen 16S RNA diamplifikasi dengan PCR menggunakan primer universal dengan produk sekitar 1300 bp. Produk PCR dirunut dengan metode Big-Dye termination. Hasilnya disepadankan dan dianalisis dengan MEGA 6.0. Pada penelitian ini, 14 spesies bakteri yang memiliki > 99% kesamaan dengan data GenBank teridentifikasi, yaitu Photobacterium leiognathi, Uruburuella testudinis, Aeromonas molluscorum, Psychrobacter celer, Psychrobacer faecalis, Acinetobacter johnsonii, Vibrio gallicus, Bacillus megaterium, Vagococcus fessus, Shewanella baltica, Shewanella algae, Rothia nasimurium, Myroides phaeus dan Yersinia ruckeri. Peran bakteri-bakteri tersebut dalam biologi ikan dan kesehatan masyarakat perlu dikaji lebih lanjut.
Kata kunci : Ikan tongkol, bakteri, 16S rRNA
ABSTRACT
Tongkol fish (Euthynnus affinis) is a favorite fish consumed by communities. The knowledge of bacteria residing in this fish is important for public health as well as for the biology of the fish. The main aim of this study was to identify bacteria associated with the tongkol fish. Samples were collected aseptically from the fish gut and inoculated into Blood Agar and Nutrient Broth. Total DNA was isolated using chelax from liquid agar, and the 16S RNA gene was amplified using PCR with universal primer set which generated 1300 bp fragments. The PCR product was sequenced using Big-Dye termination method. The sequence was aligned and analyzed using MEGA 6.0. Fourteen bacterial species with >99% nucleotide homology to GenBank data, were identified. These species included Photobacterium leiognathi, Uruburuella testudinis, Aeromonas molluscorum, Psychrobacter celer, Psychrobacer faecalis, Acinetobacter johnsonii, Vibrio gallicus, Bacillus megaterium, Vagococcus fessus, Shewanella baltica, Shewanella algae, Rothia nasimurium, Myroides phaeus and Yersinia ruckeri. The role of those bacteria in public health and the biology of the fish needs to be further elucidated.
Keywords: tongkol fish, bacteria, 16S rRNA
PENDAHULUAN
Ikan tongkol merupakan ikan yang memiliki kandungan protein tinggi (21,6-26,3 g/100 g) dan merupakan ikan yang banyak diminati oleh masyarakat karena kandungan proteinnya yang hampir sama dengan ikan tuna, namun harganya lebih terjangkau (Milo, et al., 2011). Ikan tongkol merupakan bahan pangan yang mudah rusak, sama seperti ikan dari famili scombridae lainnya. Penurunan kualitas dapat terjadi segera setelah ikan tersebut mati, dan salah satu penyebab penurunan
mutu ini adalah kontaminasi bakteri (Djafaar, 2007 dan Rahayu, et al., 1992).
Bakteri pada ikan tongkol dan ikan lain belum banyak diungkap di Indonesia. Pengetahuan ini penting untuk mengetahui kaitan konsumsi ikan dengan kesehatan masyarakat, contohnya reaksi alergi yang dapat timbul setelah mengkonsumsi ikan tongkol yang sudah mengalami penurunan mutu (Putro, 2008). Disamping itu, pengetahuan itu akan menjadi dasar yang baik untuk kajian biologi ikan.
METODE PENELITIAN
Ikan tongkol yang dijadikan sampel diambil sebanyak 10 ekor dari Pasar Ikan Kedonganan Bali lalu dibedah dengan menggunakan pinset dan gunting.Isi usus bagian belakang ikan yang dekat dengan anus diambil secara aseptis dan dimasukkan ke dalam tabung ependrof.
Penanaman bakteri dilakukan pada 2 media, media pertama adalah media Blood Agar yang merupakan media pembiakan bakteri secara umum, setelah koloni tumbuh pada media padat yang diinkubasi selama 24 jam di suhu 37 0C, diambil sebanyak 5 koloni yang secara kasat mata terlihat bebeda satu sama lain, dari warna, permukaan maupun bagian tepi koloni yang tumbuh untuk diinokulasi pada media kedua yaitu media nutrient broth(media cair). Setelah tumbuh pada media cair, suspensi sel diambil sebanyak 100 μL untuk diwarnai dengan pewarnaan Gram, dan diekstraksi untuk mendapatkan DNA bakteri.
Ekstraksi dilakukan dengan menggunakan chelex 10% yang tersusun atas styrenedivinylbenzenecopolymers, ion iminodiacetate dan resin yang berfungsi untuk mengikat Mg2+ yang terdapat dalam DNAasses (enzim yang terdapat di jaringan tubuh) agar tidak mampu mendegradasi DNA pada sampel. Sebanyak 100 μl media cair yang diinokulasi dengan bakteri dipipet dan dimasukkan ke dalam tabung ependrof untuk disentrifuse selama 5 menit pada kecepatan 5000 rpm, supernatannya dibuang, dan pellet bakterinya dicampur dengan chelex. Setelah itu, chelex divortex selama 30 detik, disentrifuse selama 1 menit pada kecepatan 8000 rpm, diinkubasi pada suhu 950C selama 30 menit, divortex kembali selama 30 detik, dan disentrifuse selama 1 menit pada kecepatan 8000 rpm.
Amplifikasi DNA bakteri menggunakan primer 16S rRNA menurut prosedur yang dilakukan Marchesi et al., (1998) dan Obsorn et al., (2000). Primer forward untuk gen bakteri adalah 63f dengan sekuens5’– CAGGCCTAACACATGCAA GTC–3’dan untuk primer reversenya adalah 1387r dengan sekuens 5’– GGGCGGWGTGTACAAGGC–3’. PCR reaction mixes sebanyak 25 μL terdiri dari 14.5 μL ddH2O, 2.5 μl 10X PCR Buffer (hot start), 2.5 μL dNTPs (8 mM), 2.0 μL MgCl2Solution (25 mM), 1.25 mL dari masing-masing primer (10 μM), 0.125 μL Amplitaq hot start(5 units/ μL) dan 1 μL DNA template. Amplifikasi dilakukan menggunakan menggunakan alat Thermal Cycler (Applied Biosystem) dengan tahapan : Pre-PCR selama 10 detik pada suhu 80°C, dilanjutkan dengan suhu 94°C selama 15 detik. PCR dilakukan sebanyak 35 siklus : denaturasi selama 1 menit pada suhu 94°C, annealing selama 1 menit pada suhu 58°C, dan extention selama 1 menit pada suhu 72°C. Setelah 35 siklus diselesaikan, dilakukan Post PCR selama 5 menit pada suhu 72°C dan 1 menit pada suhu 24°C.
Setelah amplifikasi, sebanyak 4 μL produk PCR ditambahkan dengan 1μL Loading Dye (Bromphenol-
blue dan Cyline Cyanol) dan selanjutnya dielektroforesis pada agarose 1% (0,75 gram agarose ditambah dengan 75 mL Buffer) yang telah diisi etidium bromide (EtBr). Elektroforesis dilakukan pada tegangan 100V, dengan arus 400 mA. Pada proses elektroforesis ini digunakan low mass markerDNA Ladder (invitrogen). Elektroforesis dilakukan selama 30 menit, dan hasilnya divisualisasi di bawah sinar ultraviolet dan difoto menggunakan kamera digital. Hasil positif yang diperoleh dikirim ke Berkeley Sequencing Facility di USA untuk dilakukan sekuensing. Hasil sekuensing dianalisis dengan menggunakan program MEGA.6. Setelah dirunut pada MEGA.6, hasil runutan di BLAST pada situs NCBI untuk membandingkan sekuen yang didapat dengan data yang pada GenBank.
HASIL DAN PEMBAHASAN
Hasil
Koloni bakteri yang tumbuh pada media Blood Agar dan hasil amplifikasi DNA yang divisualisasi dengan sinar UV ditunjukkan berturut-turut pada Gambar 1 dan Gambar 2.
Gambar 1. Koloni yang tumbuh pada media Blood Agar berwarna putih.
Pada gambar 2 tampak dengan jelas bahwa 16S rRNA bakteri yang diamplifikasi dengan menggunakan primer 63f dan 1387r menghasilkan fragment-fragment dengan panjang basa sebesar 1200 bp dengan intensitas cukup tinggi.
Pada tahap sekuensing yang dilakukan di Berkeley Sequencing Facility, USA, diperoleh hasil bahwa 35 produk PCR dapat disekuen dan dapat terbaca dengan baik.Panjang sekuens berada pada kisaran 461 – 1244 bp. Data sekuens ini sudah diregistrasi di GenBank dengan kode akses KM007038 – KM007072. Spesies yang dikonfirmasi menunjukkan homologi ≥ 99% dengan data sekuens yang ada pada GenBank. Hal ini berdasarkan pada publikasi Hagstrom et al. (2000) yang mengatakan bahwa bila suatu isolat dengan sekuens 16S rRNA yang homologinya lebih besar dari pada 97% dengan data sekuens yang ada pada GenBank, maka nama spesies isolat tersebut sama dengan spesies yang ada pada data GenBank (Tabel 1).
Berdasarkan pada data homologi isolat yang diperoleh

Gambar 2. Hasil PCR yang divisualisasi pada agarose 1%.Pada lajur kiri adalah marker Low mass DNA ladder (invitrogen). Posisi panjang basa (bp) pada marker itu ditunjukkan dalam gambar sampel 1-7 berturut-turut B1, B2, C5, F5, G3, dan I1.
pada penelitian ini yang dibandingkan dengan data yang ada pada GenBank, maka diperoleh identitas isolat seperti yang ditampilkan pada Tabel 2.
Pembahasan
Keberadaan bakteri di alam sangat banyak dan beragam.Berdasarkan kompleksitas kebutuhan nutrisinya, sebagian besar bakteri – bakteri tersebut tidak dapat dikultur (unculturable) secara in-vitro pada media sintetis.Hanya sebagian kecil dari bakteri tersebut dapat ditumbuhkan secara in-vitro (culturable) (Delmont et al., 2011). Fenomena yang samajuga berlaku pada bakteri yang hidup berasosiasi dengan ikan tongkol.
Berdasarkan penelitian ini, sebanyak 14 spesies bakteri dapat teridentifikasi yaitu Photobacterium leiognathi, Rothia nasinurium, Psychrobacter celer, Bacillus megaterium, Myroides phaeus, Psychrobacter faecalis, Acinetobacter johnsonii, Vagococcus fessus, Vibrio gallicus, Shewanella baltica, Shewanella algae. Yersinia ruckeri, Uruburuella testudinisdan Aeromonas mulluscorum.Bakteri yang paling banyak teridentifikasi adalah Photobacterium leiognathi.Bakteri ini dapat masuk ke dalam organ tubuh ikan tongkol, karena saat fase juvenile ikan tongkol berada di permukaan laut yang hangat dan mencerna biota-biota laut yang berukuran kecil.Menurut Balows (1992) bakteri ini merupakan bakteri biota permukaan laut yang dikenal dengan sebutan bakteri berpendar.Bakteri ini juga pernah ditemukan oleh Ramaiah (1991) pada ikan kodok (Antennarius hispidus). Selain itu, bakteri ini juga ditemukan oleh Dunlap pada Chlorophthalamus albatrossis di tahun 2005 dan pada silver ponyfish (Nuchecuquula nuchalis) pada tahun 2008.
Acinetobacter johnsonii yang ditemukan pada penelitian ini kemungkinan disebabkan ikan yang dijadikan sampel berada di area laut yang tercemar
Tabel 1 Takson dalam pusat data GenBank dengan sekuen gen 16S rRNA yang paling mirip dengan sekuen parsial masing-masing isolat
|
Nam isola |
at Spesies yang teridentifikasi |
Ho-molo-gi (%) |
Accession Number |
Kode Akses data yang diperoleh dari GenBank |
|
A1 |
Photobacterium leiognathi |
99 |
AB243239.1 |
KM007038 |
|
A2 |
Photobacterium leiognathi |
99 |
AB243239.1 |
KM007039 |
|
A3 |
Uruburuella testudinis |
99 |
JX966324.1 |
KM007040 |
|
A5 |
Photobacterium leiognathi |
99 |
AB243239.1 |
KM007041 |
|
B1 |
Photobacterium leiognathi |
99 |
FJ240416.1 |
KM007042 |
|
B2 |
Photobacterium leiognathi |
100 |
AB243250.1 |
KM007043 |
|
B3 |
Photobacterium leiognathi |
99 |
AB243250.1 |
KM007044 |
|
B4 |
Photobacterium leiognathi |
100 |
AB243245.1 |
KM007045 |
|
B5 |
Photobacterium leiognathi |
99 |
AB243245.1 |
KM007046 |
|
C1 |
Photobacterium leiognathi |
99 |
AB243250.1 |
KM007047 |
|
C2 |
Rothia nasimurium |
100 |
JX501729.1 |
KM007048 |
|
C3 |
Bacillus megaterium |
100 |
KF956576.1 |
KM007049 |
|
C4 |
Photobacterium leiognathi |
99 |
AB243250.1 |
KM007050 |
|
C5 |
Rothia nasimurium |
100 |
|JX501729.1 |
KM007051 |
|
D1 |
Photobacterium leiognathi |
99 |
AB243239.1 |
KM007052 |
|
D2 |
Photobacterium leiognathi |
99 |
AB243239.1 |
KM007053 |
|
D3 |
Photobacterium leiognathi |
99 |
AB243239.1 |
KM007054 |
|
D4 |
Photobacterium leiognathi |
100 |
AB243239.1 |
KM007055 |
|
E1 |
Psychrobacter celer |
99 |
KF471505.1 |
KM007056 |
|
E2 |
Psychrobacter celer |
99 |
JX501675.1 |
KM007057 |
|
E3 |
Psychrobacter faecalis |
99 |
KJ401058.1 |
KM007058 |
|
F1 |
Vagococcus fessus |
98 |
NR_025360.1 |
KM007059 |
|
F2 |
Vibrio gallicus |
99 |
AJ440009.1 |
KM007060 |
|
F4 |
Psychrobacter celer |
100 |
JX501675.1 |
KM007061 |
|
F5 |
Psychrobacter celer |
99 |
JF710993.1 |
KM007062 |
|
G2 |
Myroides phaeus |
99 |
GU253339.1 |
KM007063 |
|
G3 |
Acinetobacter johnsonii |
99 |
KJ623585.1 |
KM007064 |
|
G4 |
Acinetobacter johnsonii |
100 |
KF049130.1 |
KM007065 |
|
G5 |
Shewanella baltica |
100 |
KC969079.1 |
KM007066 |
|
H4 |
Myroides phaeus |
99 |
GU253339.1 |
KM007067 |
|
H5 |
Shewanella algae |
99 |
KF896607.1 |
KM007068 |
|
I1 |
Aeromonas molluscorum |
99 |
NR_115351.1 |
KM007069 |
|
I2 |
Aeromonas molluscorum |
99 |
NR_115351.1 |
KM007070 |
|
I3 |
Yersinia ruckeri |
99 |
KF413425.1 |
KM007071 |
|
J1: |
Aeromonas molluscorum |
100 |
NR_115351.1 |
KM007072 |
|
Tabel 2. Jumlah koloni dan haplotype dari spesies bakteri yang | ||||
|
diidentifikasi dari ikanTongkol asal Pasar Ikan Kedongan Bali | ||||
|
No |
Spesies yang ditemukan |
Jumlah koloni haplotipe | ||
|
1 2 |
Photobacterium leiognathi Uruburuella testudinis |
14 1 |
3 | |
|
3 4 |
Rothia nasimurium Bacillus megaterium |
2 1 |
1 | |
|
5 6 7 8 |
Psychrobacter celer Psychrobacter faecalis Vagococcus fessus Vibrio gallicus |
4 1 1 1 |
3 | |
|
9 |
Myroides phaeus |
2 |
2 | |
|
10 11 12 |
Acinetobacter johnsonii Shewanella baltica Shewanella algae |
2 1 1 |
2 | |
|
13 14 |
Aeromonas molluscorum Yersinia ruckeri |
3 1 |
3 | |
oleh minyak. Menurut Kuan Wang, et al., (2009) bakteri Acinetobacter johnsonii terdapatpada sampel minyak yang diambil di salah satu pelabuhan di China dan Lee et al., (2012), menyatakan bahwa Acinetobacter johnsonii merupakan bakteri yang menggunakan minyak sebagai sumber energi. Acinetobacter johnsonii merupakan bakteri yang patogen pada ikan.Hal ini dibuktikan oleh Kozinska, et al., (2014) pada ikan trout pelangi di Polandia. Bakteri ini memiliki gen yang mengekspresikan resistansi pada antibiotik.
Rothia nasimurium juga ditemukan diantara koloni sampel ikan tongkol.Bakteri ini merupakan flora normal pada manusia (Daneshvar et al., 2004).Keberadaan bakteri ini pada sampel ikan tongkol bisa disebabkan oleh kontaminasi saat pengerjaan inokulasi.Berdasarkan penelitian Kwan Soo, et al. (2009), Rothia nasimuruim ditemukan pada darah manusia.Selain pada manusia, bakteri ini juga pernah diisolasi dari Panda oleh Yingzhi pada tahun 2013.Bakteri ini pernah dilaporkan sebagai penyebab infeksi serius seperti endocarditis dan bakterimia (Daneshvar et al., 2004).
Vibrio gallicus teridentifikasi pada penelitian ini.Bakteri ini ditemukan pada ikan tongkol karena merupakan salah satu biota yang hidup di laut.Bakteri ini pernah ditemukan oleh Sawabe, et al., (2004) pada abalone (Haliotis tuberculata). Selain itu, Austin and Austin(2007) juga menemukan pada ikan trout (Oncorhynchus mykiss) dan dilaporkan sebagai bakteri yang patogen.
Bakteri lain yang ditemukan adalah Aeromonas molluscorum. Bakteri ini ditemukan pada ikan tongkol dikarenakan bakteri ini merupakan mikroba laut.Menurut Austin and Austin (2007), bakteri ini merupakan bakteri patogen di perairan laut yang menyebabkan septicaemia dan hemorrhagic pada ikan.Selain pada ikan, bakteri Aeromonas molluscorum ini pernah ditemukan pada kerang laut oleh Minana-Galbis di tahun 2004.
Psychrobacter merupakan bakteri gram negatif. Pada penelitian ini ditemukan 2 spesies bakteri dari genus yang sama yaitu Psychrobacter celer dan Psychrobacter faecalis. Kedua bakteri ini merupakan bakteri flora normal dari biota laut.Hal ini diperkuat oleh penelitian dari Gonzales pada tahun 2000 yang mengatakan bahwa banyak bakteri yang berhubungan dengan ikan dari perairan, seperti dari genus Psychrobacter.Selain itu, Jung-Hoon (2005) berhasil mengisolasi Psychrobacter celer dari pantai utara Korea.
Yersinia ruckeri merupakan salah satu bakteri yang ditemukan pada penelitian ini.Belum pernah ada penelitian tentang bakteri ini pada ikan tongkol. Hal ini berdasarkan dari 2 penelitian tentang Yersinia ruckeri oleh Akhlaghi (2008) dan Tobback (2009), yang mengatakan bahwa bakteri ini ditemukan pada ginjal ikan trout (Oncorhyncus mykiss) dan bakteri ini juga merupakan salah satu biota laut yang menyebabkan patogenitas pada ikan maupun manusia.
Shewanella merupakan genus bakteri yang patogen pada manusia dan binatang perairan.Bakteri ini dapat
menyebabkan bakterimia(Aspiroz, et al., 2004).Pada penelitian ini, ditemukan 2 spesies dari genus Shewanella yaitu Shewanella algae dan Shewanella baltica.Pada penelitian Vikas (2012), Shewanella algae diisolasi dari jaringan tubuh terinfeksi dari pasien diabetes.Shewanella baltica belum teridentifikasi dengan baik dan belum ada publikasi tentang penelitian dari bakteri ini.
Bacillus merupakan bakteri Gram positif yang paling sering ditemukan di alam.Seperti misalnya pada penelitian ini, ditemukan satu spesies bacillus yang merupakan salah satu mikroba dari biota laut yaitu Bacillus megaterium.Rodrigues-Contreras (2013) mengatakan pada penelitiannya bahwa Bacillus megaterium merupakan bakteri yang hidup di lingkungan perairan yang tingkat salinitasnya tinggi.
Uruburuella merupakan bakteri gram negatif.Bakteri ini merupakan bakteri yang unik dan langka.Pengetahuan tentang bakteri ini sangat minim.Pada penelitian ini ditemukan bakteri Uruburuella testudisnis.Penelitian tentang bakteri ini belum pernah dipublikasi oleh penemunya, sehingga belum dapat dipastikan asal dari bakteri ini atau peran bakteri ini.
Beberapa bakteri yang ditemukan pada penelitian ini dapat menyebabkan penyakit seperti Bakterimia dan septicaemia. Bakterimia dan septicaemia merupakan penyakit yang disebakan oleh adanya bakteri di dalam aliran darah. Fakor penyebab pemicu bakterimia dan septicaemia adalah adanya perubahan sistem pertahanan tubuh manusia (Wibowo, 2006).Perubahan ini bisa disebabkan oleh penyakit atau tindakan seperti pemasangan infus.Penderita bakterimia dapat sembuh tanpa pengobatan apapun, karena gejala yang ditimbulkan pada bakterimia hanya meriang, sakit pada bagian perut dan demam. Untuk septicaemia, infeksi yang disebabkan oleh bakteri ini menyebar atau bereaksi secara cepat dan akan menyebabkan sakit yang serius yang dapat mengancam nyawa dari penderita (Hall, et al., 2011). Infeksi ini dapat timbul di seluruh bagian tubuh, seperti paru-paru, perut dan saluran kemih.Pasien yang mengidap septicaemia harus segera dirawat pada bagian ICU (Intensive Care Unit).Gejala yang timbul ada pasien septicaemia adalah demam, nafas cepat, menggigil, dan detak jantung cepat. Namun gejala ini akan cepat berubah menjadi penurunan suhu tubuh yang drastis (hipotermia), penurunan tekanan darah, kebingungan atau perubahan lain dalam status mental dan penggumpalan darah yang menimbulkan bintik-bintik merah pada kulit (Hall, et al., 2011).
Fenomena keragaman genetik pada berbagai spesies bakteri juga tampak pada penelitian ini.Istilah haplotipe diberikan mengingat bahwa kromosom bakteri bersifat haploid, mirip dengan mitokondria eukariot (Madigan et al., 2009).Sebanyak masing-masing tiga variasi sekuens ditemukan pada Photobacterium leiognathi dan Aeromonas molluscurum, sedangkan 2 variasi sekuens ditemukan pada Myroides phaeus dan Acinetobacter johnsonii.
Simpulan dan Saran
Hasil penelitian diperoleh 14 spesies bakteri yang berasosiasi dengan saluran pencernaan ikan tongkol. Spesies bakteri yang paling dominan teridentifikasi dari sampel usus ikan tongkol adalah Photobacterium leiognathi.
Bakteri-bakteri yang ditemukan pada penelitian ini, beberapa merupakan bakteri yang patogen baik bagi ikan maupun manusia.Peran bakteri ini perlu dikaji lebih lanjut.
KEPUSTAKAAN
Akhlaghi, M. and Y.H. Sharifi. 2008. Detection and Identification of Virulent Yersinia Ruckeri : The Causative Agent of Enteric Redmouth Disease in Rainbow Trout (Oncorhynchus mykiss) Cultured in Fars Province, Iran. Iranian Journal of Veterinary Research, Shiraz University Vol. 9No. 4, Ser. No. 25 : 347 – 352.
Aspiroz C., C. Navarro, E. Aguilar, M. Rodriguez-Andres. 2004. Bacteremia in an Obese Patient with Cellulitis and Chronic Ulceration in the Lower Extremity. Enferm.Infec.Microbiol. Clin.22: 363-364.
Austin, B., D. A. Austin. 2007. Bacterial fish pathogens, disease of farmed and wild fish (4th edition) Springer-Praxis, ISBN 978-1-4020-6068-7, Chichester, UK.
Balows, A. 1992.The Prokaryotes.2nd ed. Vol. 2. Springer-Ver Log : New York City
Daneshvar, M.I., D.G. Hollis, R.S. Weyant, J.G. Jordan, J.P. MacGregor, R.E. Morey, A.M. Whitney, D.J. Brenner, A.G. Steigerwalt, L.O. Helsel, P.M. Raney, J.B. Patel, P.N. Levett, J.M. Brown. 2004. Identification of somecharcoal-black-pigmented CDC fermentative coryneform group 4 isolates as Rothia dentocariosa. J. Clin.Microbiol.42 : 4189-98.
Delmont, T. O., Robe, P., Clark, I., Simonet, P., Vogel, T. M. 2011. Metagenomic comparison of direct and indirect soil DNA extraction approaches. Journal of microbiological methods, 86, (3), 397-400.
Djaafar, T. F. dan S. Rahayu. 2007. Cemaran Mikroba Pada Produk Pertanian, Penyakit yang Ditimbulkan dan Pencegahannya. Jurnal Litbang Pertanian, 26 (2) : 67 – 75.
Dunlap, P.V. and C.Ast. Jennifer. 2005. Genomic and Phylogenetic Characterization of Luminous Bacteria Symbioic with The Deep-Sea Fish Chlorophhthalmus albatrossis (Autopiformes : Chlorophthalmidae). Applied and Enviromental Microbiology. 71 (2) : 930-939.
Dunlap, PV., K.M Davis, S. Tomiyama, M. Fujino and A. Fukui. 2008. Developmental and Microbial Analysis of the Inception of Bioluminescent Symbiosi in the Marine Fish Nuchecuquula nuchalis (Perciformer : Leiognathidae). Appl. Environ.Mi-crobiol.74 (24) : 7471-81.
González C.J., J.A. Santos,M.L. García-López,and A. Otero. 2000. Psychrobacters and Related Bacteria in Freshwater Fish. J. Food Prot.63 : 315–321.
Hagstrom, A., J.F. Pinhassi, and U.L. Zweiefel. 2000. Biogeogh-raphycal Diversity Among Marine Bacteriplankton. Aquatic Microbial Technology, 21:231-234.
Hall, M. J., S.N. Williams, C. J. DeFrances, and A. Golosinskiy. 2011. Inpatient Care for Septicemia or Sepsis : A Challenge for Patients and Hospitals. NCHS Data Brieff, N0 62.
Jung-Hoon, Y., L. Choong-Hwan, K. So-Jung and O. Tae-Kwang. 2005. Psychrobacter celer sp. nov., Isolated From Sea Water
of The South Sea in Korea.International Journal of Sytematic and Evolutionary Microbiology. 55:1885-1890
Kozinska, A., E. Pazdzio, Pekala, Agnieszka., and W. Niemczuk. 2014. Acinetobacter johsonii and Acinetobacter lwoffii – The Emerging of Fish Pathogens. Bull. Vet.Inst. Pulawy.58 : 193-199.
Kuan-Wang, H., J. Shao, Y. Jie-Wei, J. Zhang, and W. Qi. 2009. Amovel Low-Temperature Alkaline Lipase from Acineto-bacter johnsonii LP28 Suitable for Detergent Formulation. Food Technol. Biotechnol.49 : 96-102.
Kwan Soo, K., L. Mi Young, P. Young Kyoung, P. Kyoung Ran, and S. Jae-Hoon. 2009. Molecular Identification of Clinical Rothia Isolates From Human Patients : Proposal of a Novel Rothia Species, Rothia arfidiae sp. nov. Journal of Bacteriology and Virology.3 : 159-164.
Lee, M., S.G. Woo, L.N. Ten. 2012. Characterization of Novel DieselDegrading Strains Acinetobacter haemolyticus MJ01 AndA-cinetobacter johnsonii MJ4 Isolated from Oil-Contaminated Soil. World J. Microbiol.Biotecnol.28 (5) 2057-2067.
Madigan, M.T., J.M. Martinko, P. Dunlap, and D.P. Clark. 2009. Brock Biology of Microorganism, 12th ed. Pearson International Edition.
Marchesi J.R., T. Sato, A.J. Weightman, T.A. Martin, J.C. Fry, S.J. Hiom, W.G. Wade. 1998. Design and evaluation of useful bacterium-specific PCR primers that amplify genes coding for bacterial 16S rRNA. Appl. Environ.Microbiol.642: 795-799
Milo, M.S., L.M Ekawati, dan F. S. Pranata. 2011. Mutu Ikan Tongkol (Eythynnus affinis C.) di Kabupaten Gunungkidul dan Sleman Daerah Istimewa Yogyakarta. Fakultas Teknobiologi Universitas Atma Jaya Yogyakarta.
Minana-Galbis, D., F. Maribel, M.C. Fuste, and J.G. Loren. 2004. Aeromonas molluscorum sp. nov., Isolated from Bivalve Molluscs. International Journal of Systematic and Evolutionary Microbiology54 : 2073-2078.
Osborn A. M., E.R.B. Moore, and K.N. Timmis. 2000. An Evaluation of terminal-restriction Fragment Length Polymorphism T-RFLP Analysis for the Study of Microbial Community Structure and Dynamics. Environ.Microbiol.2: 39-50.
Ramaiah, N. and D. Chandramohan. 1991. Occurrence of Photobacterium leiognathi, as The Bait Organ Symbiont in Frogfish Antenmarius hispidus. Indian Jiurnal of Marine Sciences Vol. 21 : 210-211.
Rodriguez-Conteras, A.,M. Koller, M.M. Sousa-Dias, M. Calafell-Monfort, G. Braunegg, and M.S. Marques-Calvo. 2013. High Production of Poly(3-hydroxybutyrate) from Wild Bacillus megaterium Bolivian Strain. Journal of Applied Microbiology 114 (5) : 1378-1387.
Sawabe, T., K. Hayashi, J. Moriwaki, F.L. Thompson, J. Swings, P. Potin, R. Christen, and Y. Ezura. 2004. Vibrio gallicus sp.nov., Isolated from The Gut of The French Abalone (Hali-otis tuberculata). Int. J. syst. Evol.Microbiol.3 : 843 – 846.
Tobback, E. 2009.Early Pathogenis of Yersinia ruckeri Infections in Raoinbow Trout (Oncorhynchus mykiss, Walbaum). Faculty of Verterinary medicine, Ghent University
Vikas, G., S. Karnika, B. Ashish, and R. Pallab. 2012. Shewanella algae Soft tissue Infection in a Diabetic Patient. J. Clin.Case. Rep. 2 :217-234.
Wibowo, V.E. 2006.Faktor Risiko, Pola Kuman dan Kepekaan Kuman Penyebab Bakterimia pada Pasien Geriatri di Rumah Sakit DR. Kariadi Semarang. Fakultas Kedokteran, Universitas Diponegoro.
Yingzhi, W., L. Chen, D. Lo, L. Zhu, W. Guo and Z. Xu. 2013. Isolation and Identification of Rothia nasimurium from a Giant Panda (Ailuropoda melanoleuca). Journal of Animal and Verterinary Advances 12 (13) : 1190 – 1192.
62
Discussion and feedback